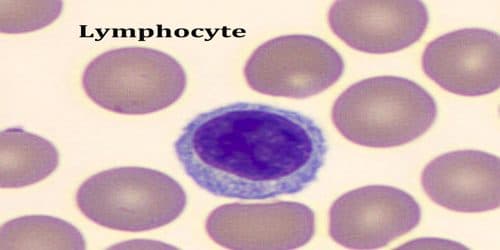
Lymphocytes là gì?

Chỉ số Lymphocytes là gì và có ý nghĩa gì trong xét nghiệm
1. Lymphocytes là gì?
1.1 Định nghĩa Lymphocytes
Lymphocytes có tên tiếng Việt là lympho bào hoặc tế bào lympho. Đây là một loại tế bào bạch cầu trong hệ miễn dịch của con người.
Chúng đóng vai trò quan trọng trong hệ thống miễn dịch, giúp cơ thể bạn chống lại bệnh tật và nhiễm trùng. Hệ thống miễn dịch được tạo thành từ một mạng lưới phức tạp của các tế bào miễn dịch, hạch bạch huyết, mô bạch huyết và các cơ quan bạch huyết. Tế bào lympho là một loại tế bào miễn dịch.
Có hai loại tế bào lympho chính:
– Tế bào lympho T (tế bào T) : Tế bào T kiểm soát phản ứng của hệ thống miễn dịch của cơ thể và trực tiếp tấn công và tiêu diệt các tế bào bị nhiễm bệnh và tế bào khối u.
– Tế bào lympho B (tế bào B) : Tế bào B tạo ra kháng thể. Kháng thể là protein nhắm vào vi-rút, vi khuẩn và các tác nhân xâm nhập lạ khác.
Tế bào T và tế bào B của bạn hoạt động cùng nhau. Mỗi loại có vai trò khác nhau trong hệ thống miễn dịch.

Lymphocytes là một loại tế bào bạch cầu trong hệ miễn dịch của con người. (ảnh minh họa)
1.2 Hoạt động của các tế bào T
Tế bào T tiêu diệt các tế bào bị nhiễm và kiểm soát phản ứng miễn dịch của cơ thể với các chất lạ. Hầu hết các tế bào T cần sự trợ giúp của một tế bào miễn dịch khác để được kích hoạt. Sau khi các tế bào T được kích hoạt, chúng nhân lên và chuyên biệt thành các loại tế bào T khác nhau. Các loại này bao gồm:
– Tế bào T gây độc (tế bào giết) : Tế bào T gây độc bám vào các kháng nguyên trên các tế bào bị nhiễm hoặc bất thường. Sau đó, chúng tiêu diệt các tế bào bị nhiễm bằng cách tạo lỗ trên màng tế bào của chúng và đưa enzyme vào tế bào.
– Tế bào T hỗ trợ : Tế bào T hỗ trợ giúp các tế bào miễn dịch khác. Một số tế bào T hỗ trợ giúp tế bào B tạo kháng thể chống lại các tác nhân xâm nhập lạ. Những tế bào khác giúp kích hoạt tế bào T gây độc.
– Tế bào T điều hòa (ức chế) : Tế bào T điều hòa tạo ra các chất giúp chấm dứt phản ứng của hệ thống miễn dịch đối với một cuộc tấn công. Đôi khi, chúng ngăn chặn các phản ứng có hại xảy ra.
1.3 Hoạt động của các tế bào B
Tế bào B có thụ thể trên bề mặt nơi kháng nguyên bám vào. Tế bào B nhận biết các kháng nguyên khác nhau và sản xuất kháng thể đặc hiệu để tấn công từng kháng nguyên. Tế bào B phản ứng với kháng nguyên theo hai cách:
– Phản ứng miễn dịch chính : Khi một kháng nguyên gắn vào thụ thể, các tế bào B được kích thích. Một số tế bào B chuyển thành tế bào nhớ. Các tế bào B khác chuyển thành tế bào plasma. Các tế bào plasma tạo ra một kháng thể đặc hiệu với kháng nguyên cụ thể đã kích thích nó. Việc sản xuất đủ kháng thể đặc hiệu đó có thể mất vài ngày.
– Phản ứng miễn dịch thứ cấp : Nếu tế bào B gặp lại kháng nguyên đó, các tế bào nhớ sẽ ghi nhớ và nhân lên. Chúng biến đổi thành tế bào plasma và nhanh chóng sản xuất kháng thể chính xác.
2. Chỉ số Lymphocytes có ý nghĩa gì?
Chỉ số Lymphocytes phản ánh lượng tế bào lympho có trong cơ thể. Đây là yếu tố quan trọng giúp bác sĩ nắm được tình trạng bệnh nhân và có thể phát hiện sớm những những vấn đề bất thường từ đó có thể chẩn đoán và điều trị kịp thời. Ở người bình thường, lượng bạch cầu thường có mức giới hạn dao động rất lớn với số lượng trung bình từ 4 – 10 G/L với tỷ lệ phần trăm lympho bào trong máu từ 17 – 48%.
Ở người lớn, phạm vi bình thường của tế bào lympho là từ 1 đến 4.8 G/L. Ở trẻ em tùy theo độ tuổi, phạm vi bình thường của tế bào lympho là từ 3 đến 9.5G/L.
Vậy chỉ số Lymphocytes tăng, giảm cảnh báo điều gì?

Lymphocytes tăng hay giảm đều ảnh hưởng đến sức khỏe và có thể gây ra nhiều bệnh lý nguy hiểm. (ảnh minh họa)
2.1 Chỉ số Lymphocytes tăng
Tăng lympho bào thường là do nhiễm trùng hoặc bệnh tật. Cơ thể sản xuất thêm tế bào lympho để giúp chống lại nhiễm trùng và bệnh tật. Nhưng một tình trạng nghiêm trọng hơn cũng có thể gây ra số lượng tế bào lympho cao, bao gồm:
– Viêm gan.
– Bệnh giang mai.
– Bệnh lao.
– HIV và AIDS.
– Suy giáp.
– Các bệnh nhiễm trùng như ho gà, bệnh toxoplasma hoặc cytomegalovirus.
– Ung thư máu như u lympho hoặc bệnh bạch cầu…
2.2. Ý nghĩa giảm chỉ số Lymphocytes là gì?
Mức tế bào lympho thấp trong máu của bạn được gọi là giảm bạch cầu lympho. Cúm hoặc các bệnh nhiễm trùng nhẹ khác có thể gây giảm bạch cầu lympho, nhưng nó cũng có thể do một căn bệnh hoặc tình trạng nghiêm trọng hơn gây ra, bao gồm:
– HIV hoặc AIDS.
– Bệnh lao hoặc thuương hàn .
– Viêm gan do virus.
– Các bệnh về máu như bệnh Hodgkin
– Các bệnh tự miễn như bệnh lupus
– Một số bệnh di truyền hiếm gặp…
– Điều trị bằng xạ trị hoặc hóa trị.
Chỉ số lymphotes giảm có thể cảnh báo các bệnh như: lao tuyến phế quản, u tủy,…
Vì chỉ số LYM có vai trò quan trọng trong việc chẩn đoán và phát hiện ra các căn bệnh lý về bạch cầu, đây là những bệnh lý rất nguy hiểm. Vì vậy bạn cần chú ý đến kết quả xét nghiệm máu, khi thấy chỉ số Lymphocytes nằm ngoài mức cho phép (cao hơn hoặc thấp hơn 17-48%), bạn nên đến các cơ sở y tế uy tín để được bác sĩ thăm khám xác định chính xác nguyên nhân và có phương pháp điều trị tốt nhất.